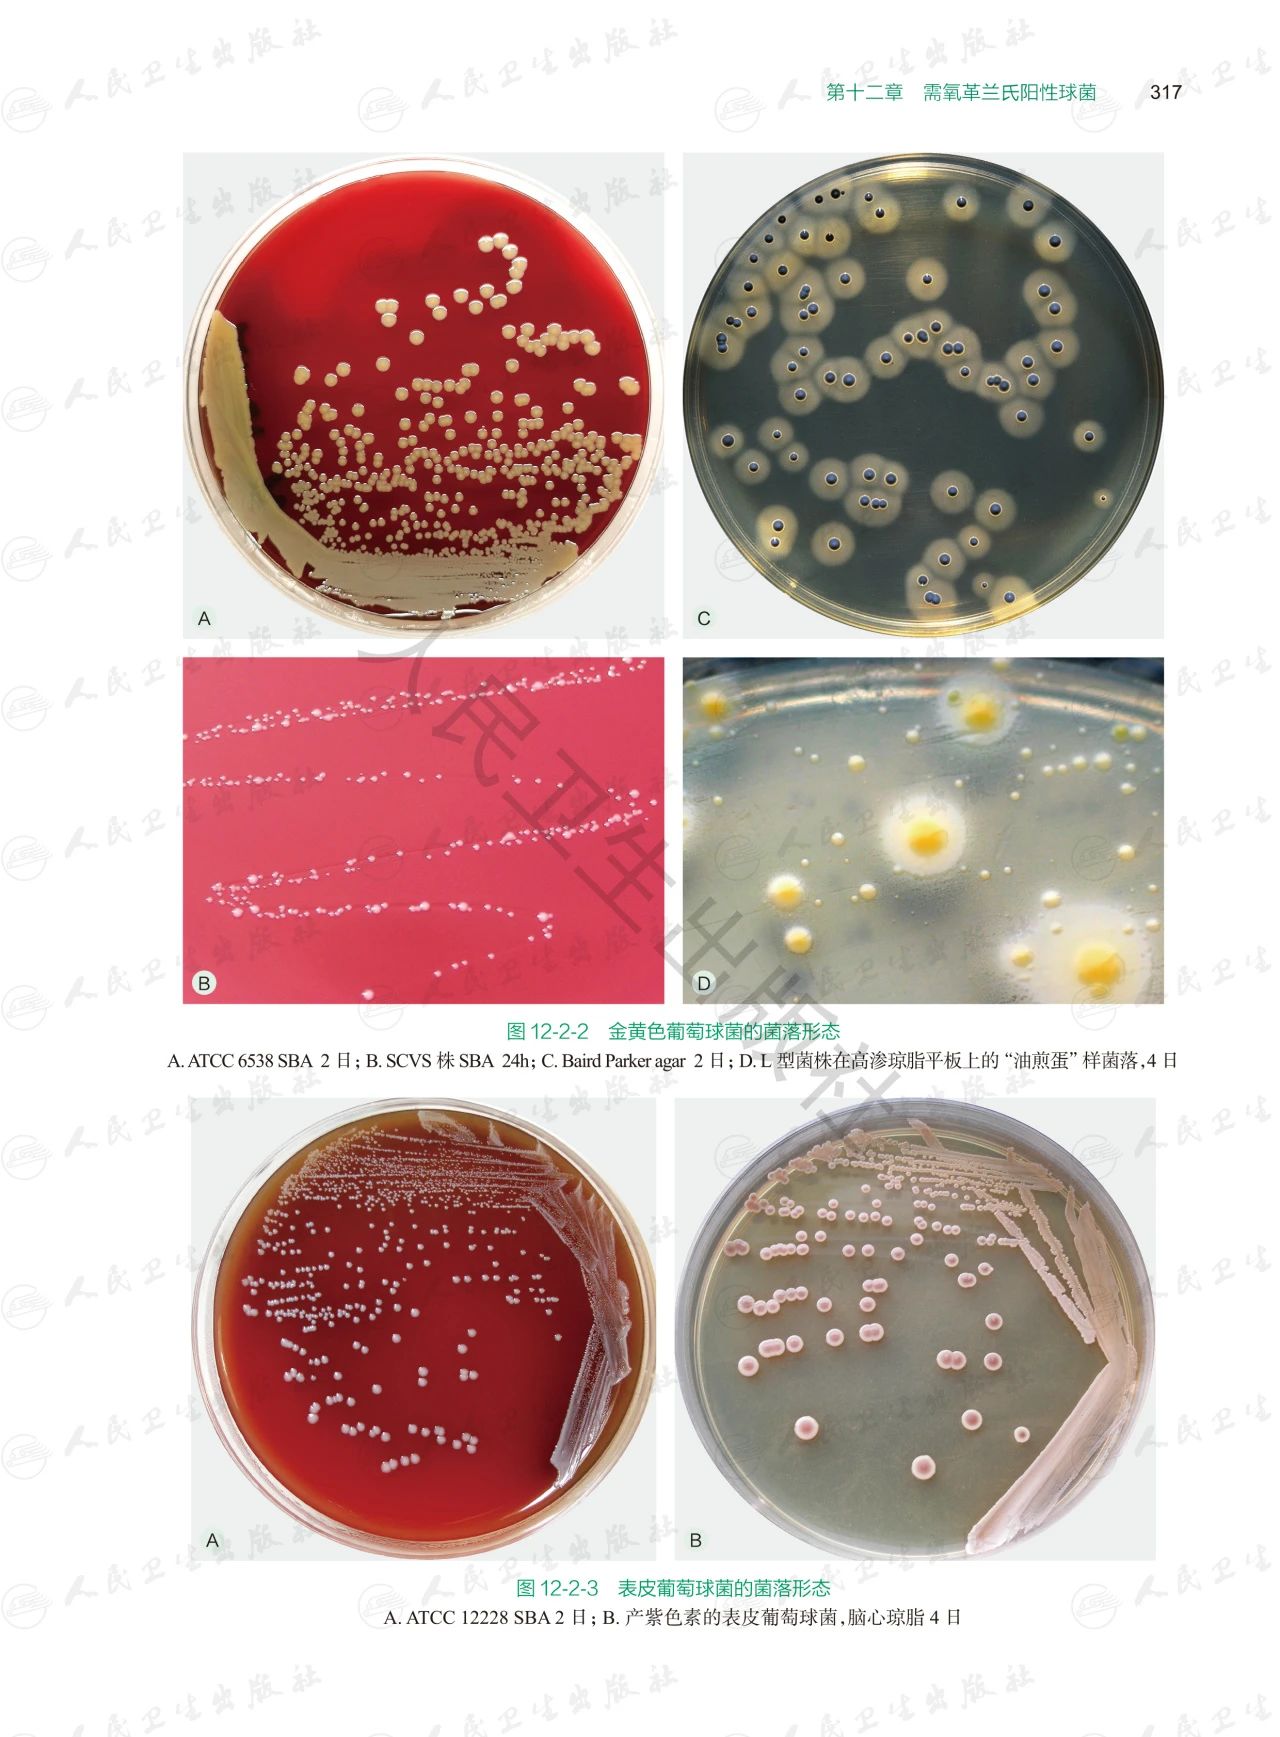
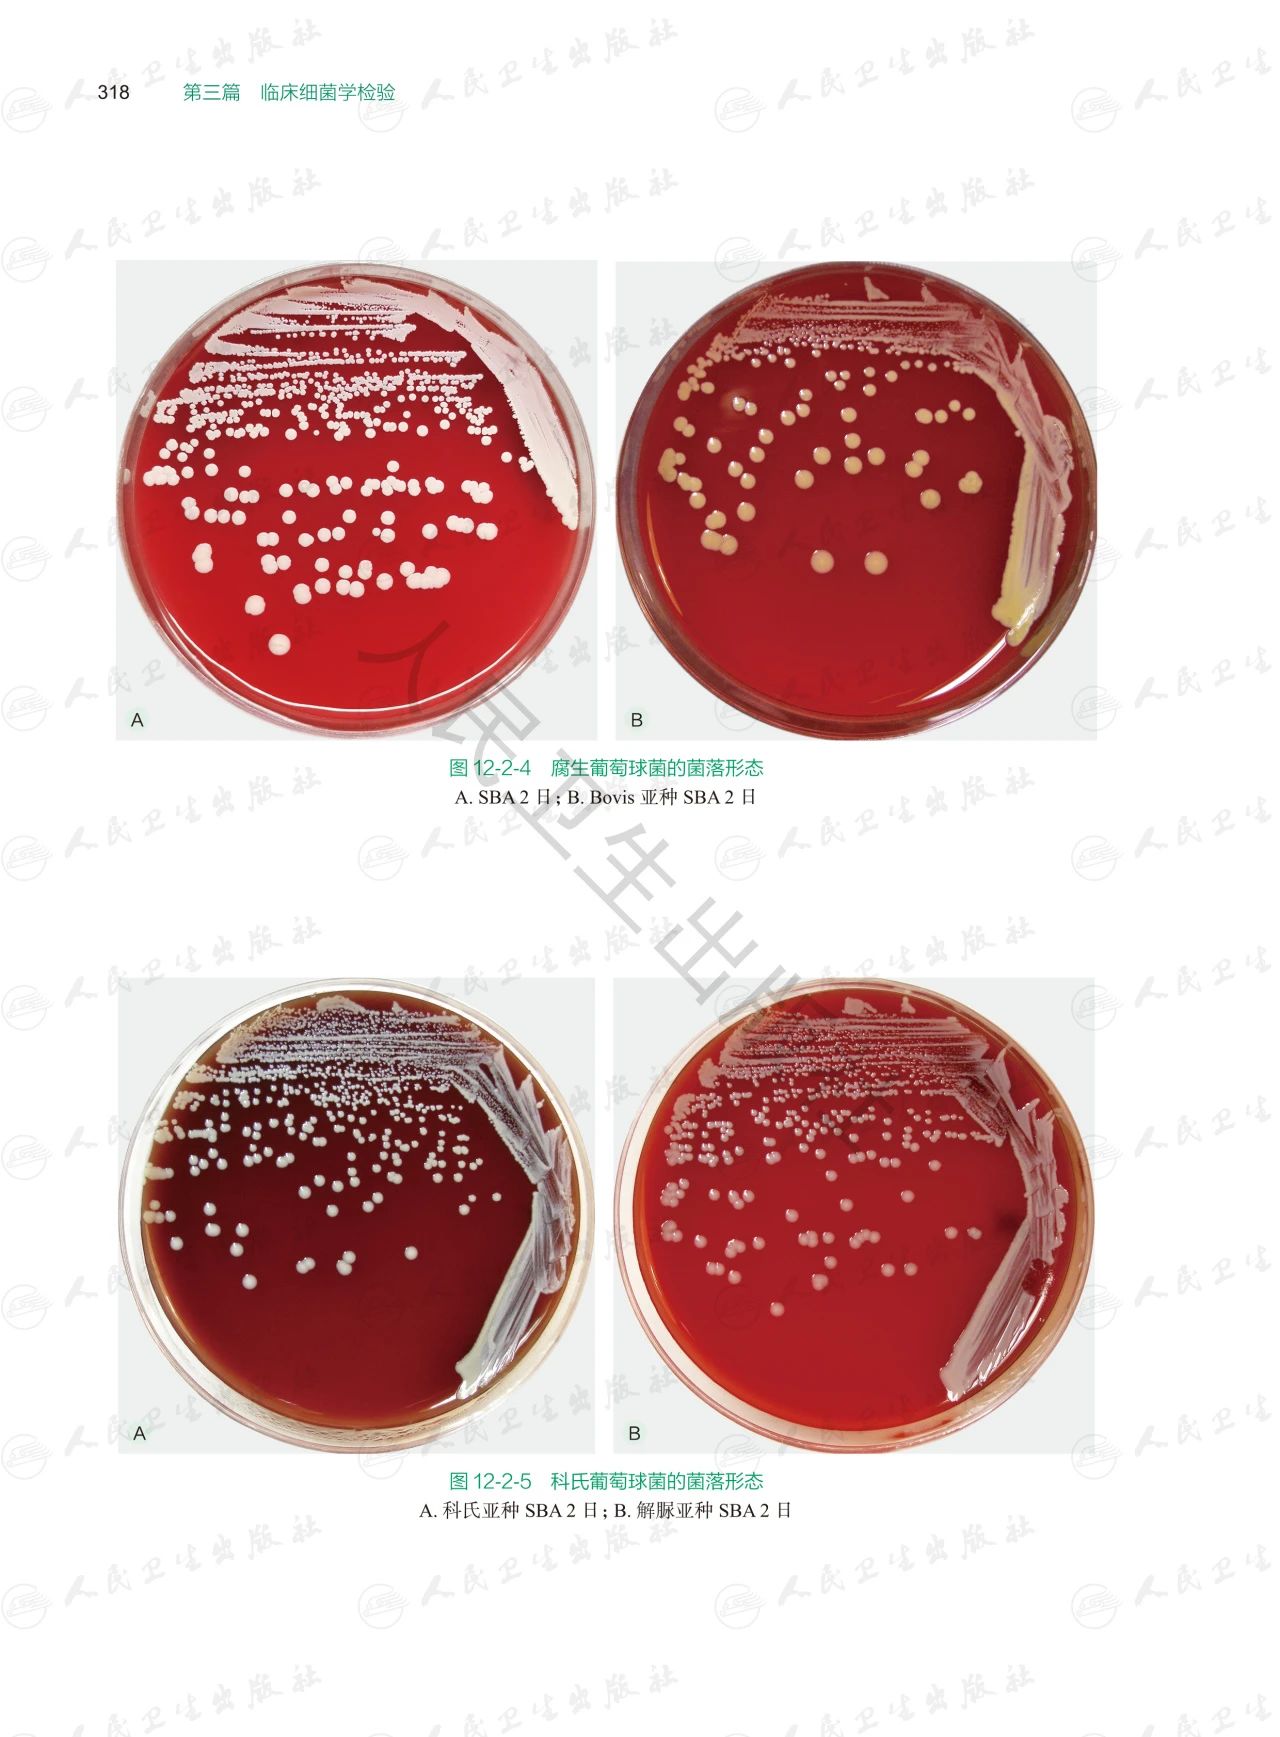
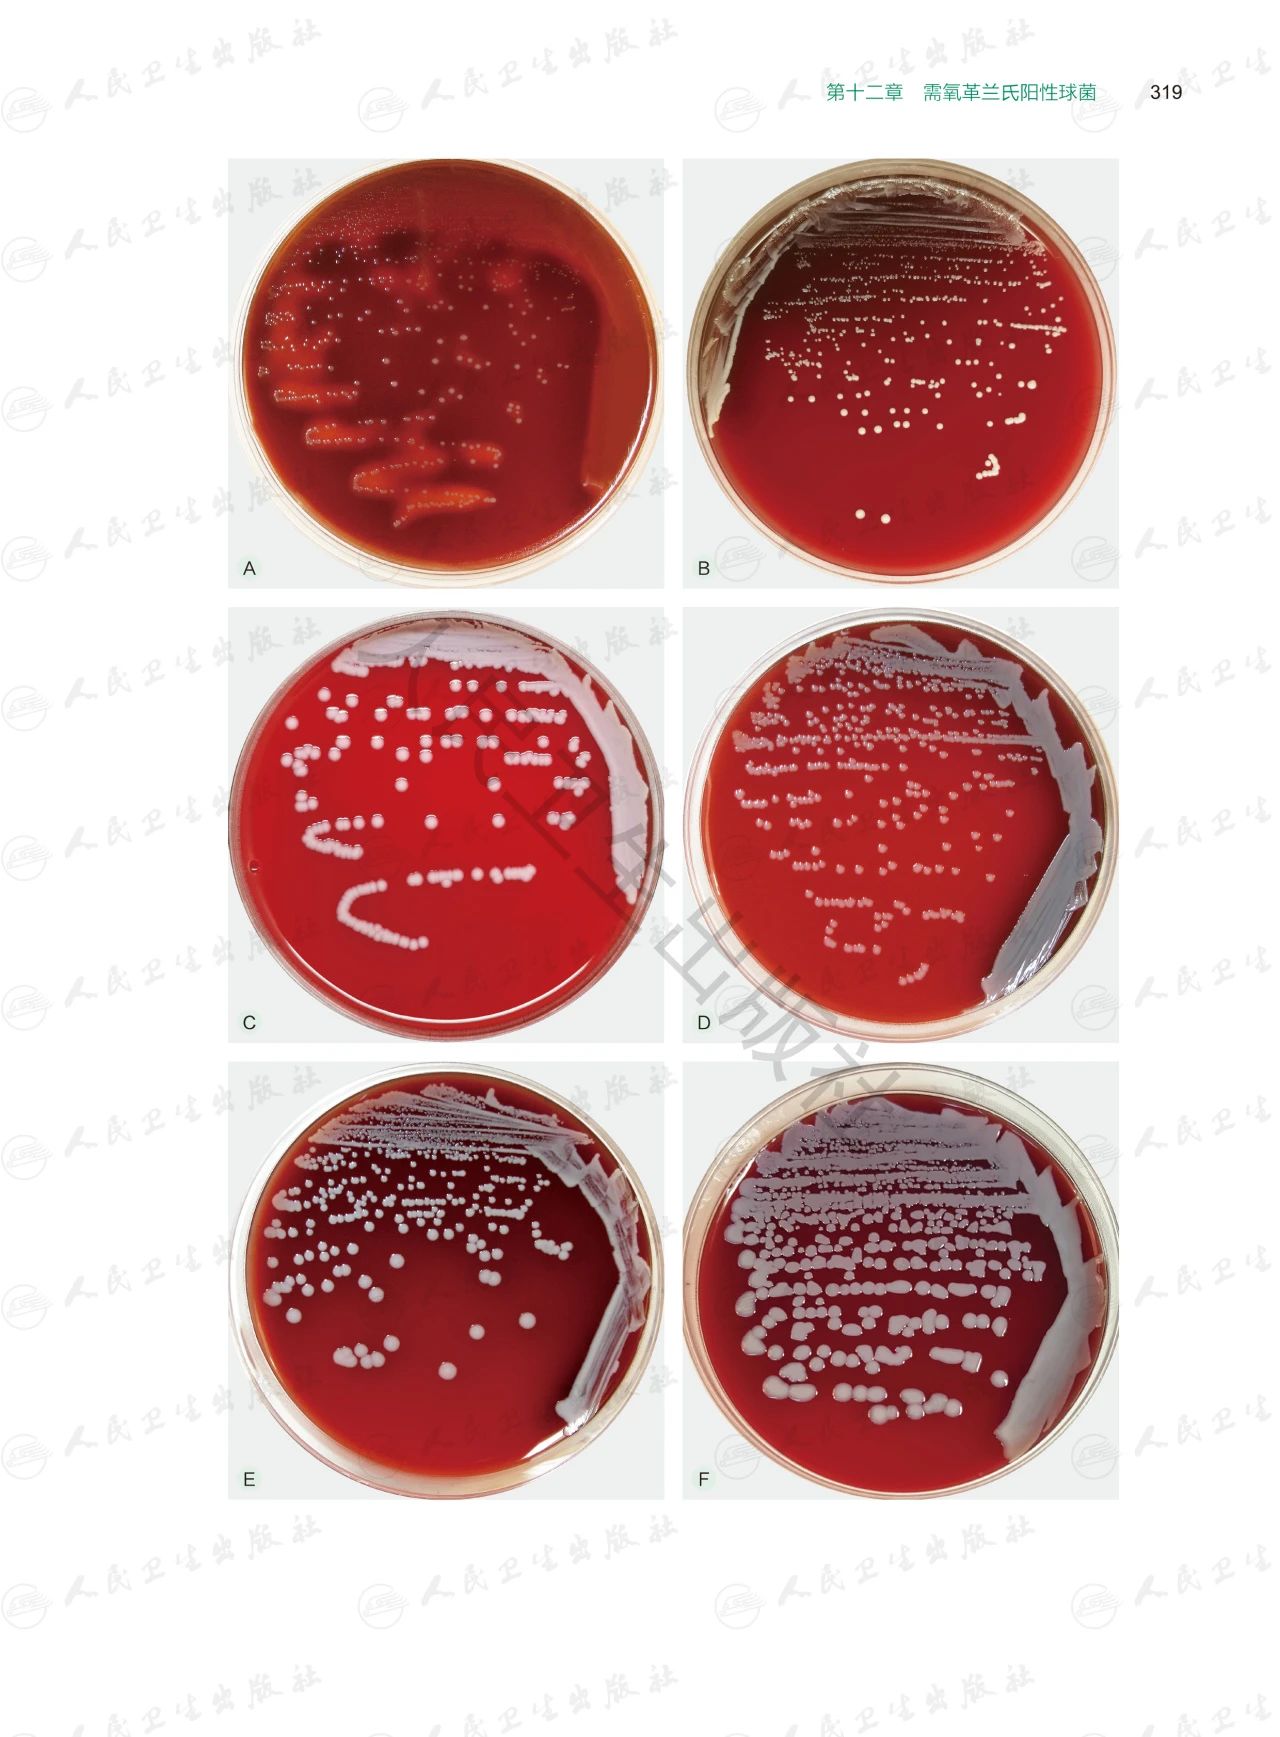
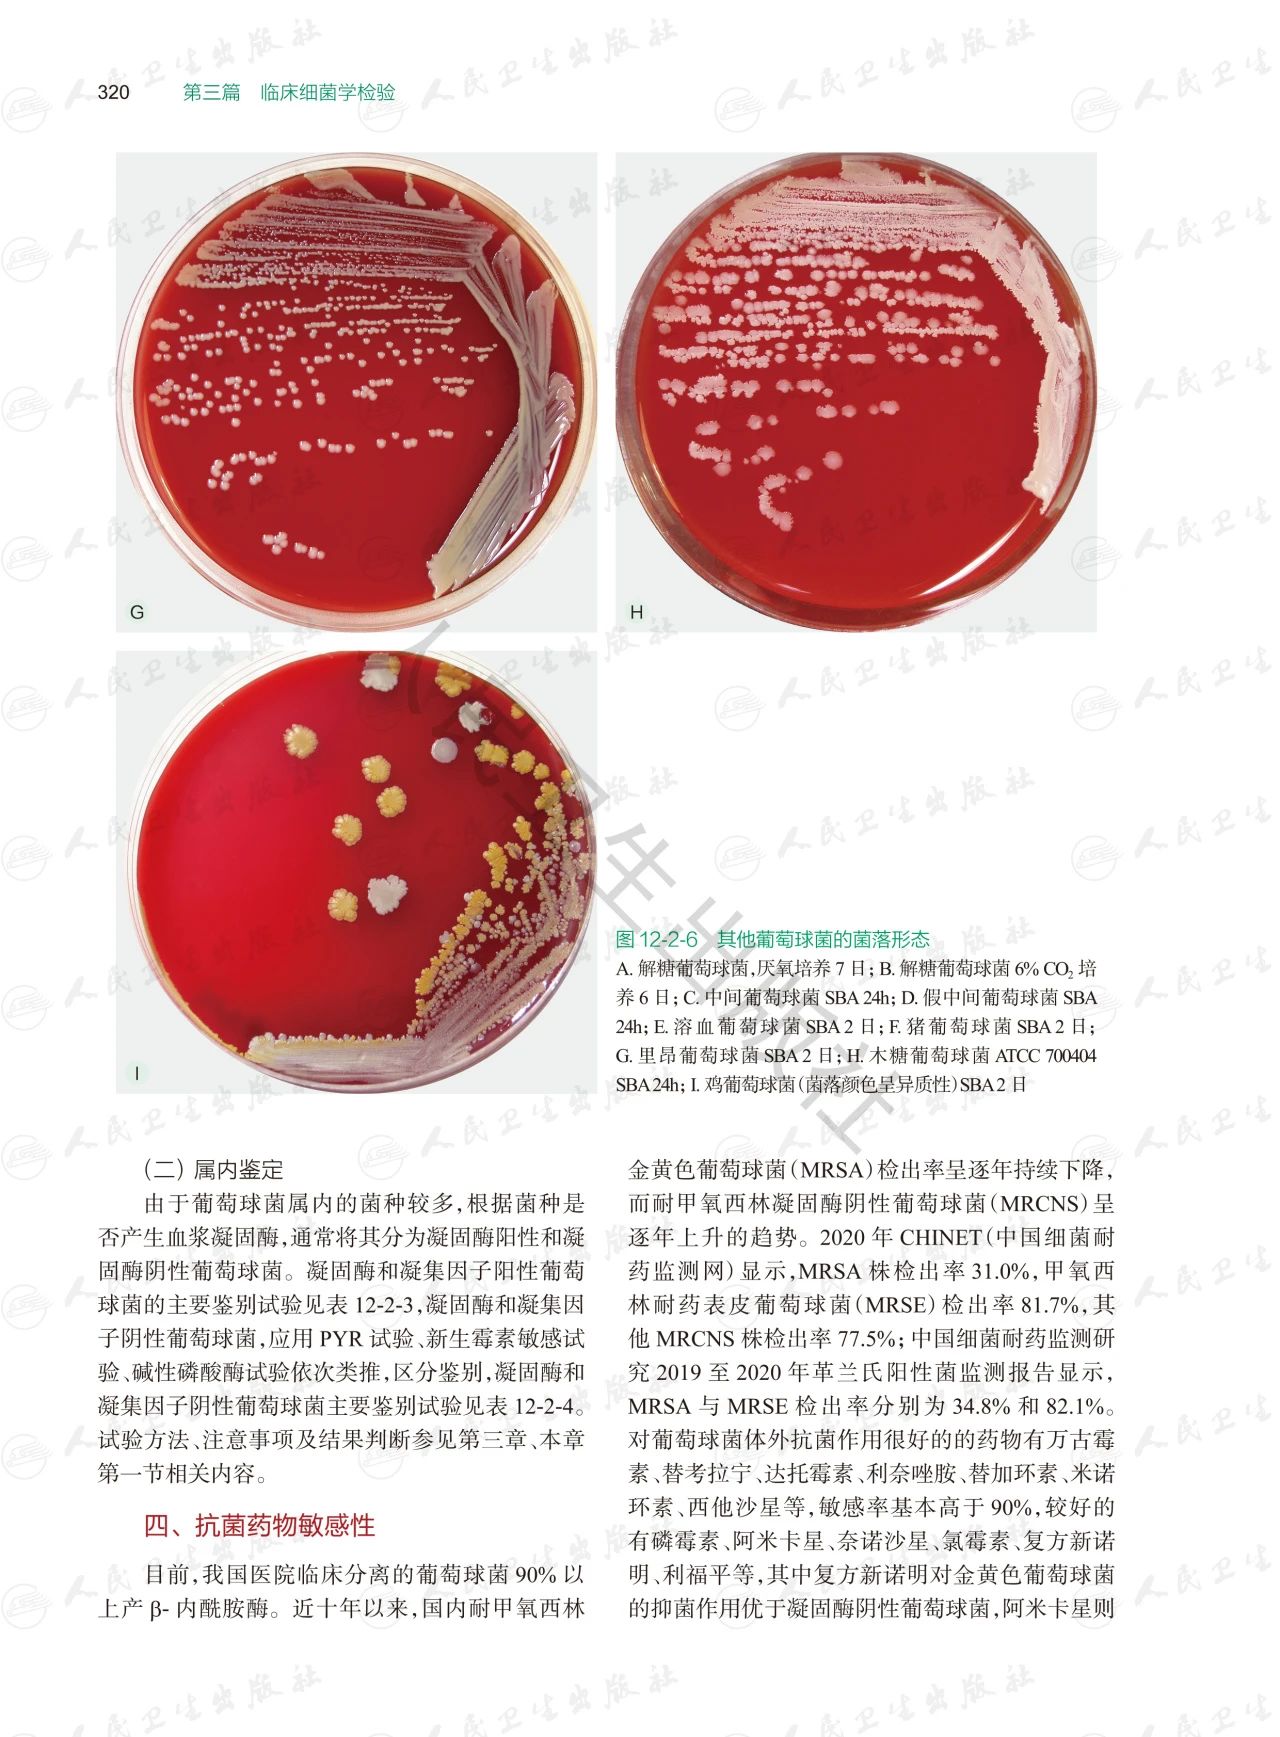

商品详情

实用临床微生物学检验与图谱(上下册)
ISBN:978-7-117-37621-1
主 编:陈东科,孙长贵,徐和平
定 价:998.00元
出版社:人民卫生出版社
内容简介 专家推荐
专家推荐 内 封
内 封 编 者
编 者 主编简介
主编简介

 前 言
前 言
 目 录
目 录







 样章试读
样章试读









- 人卫智慧服务商城 (微信公众号认证)
- 扫描二维码,访问我们的微信店铺
- 随时随地的购物、客服咨询、查询订单和物流...

实用临床微生物学检验与图谱(上下册)
ISBN:978-7-117-37621-1
主 编:陈东科,孙长贵,徐和平
定 价:998.00元
出版社:人民卫生出版社
内容简介 专家推荐
专家推荐 内 封
内 封 编 者
编 者 主编简介
主编简介

 前 言
前 言
 目 录
目 录







 样章试读
样章试读

微信支付
支付宝
扫一扫购买